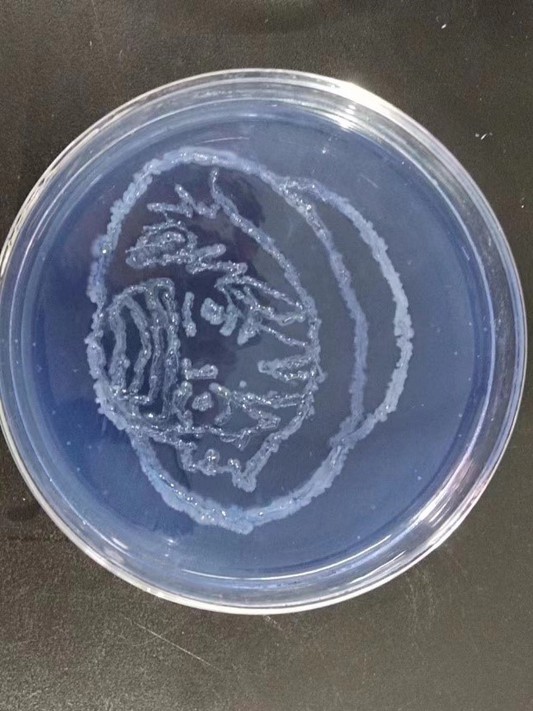
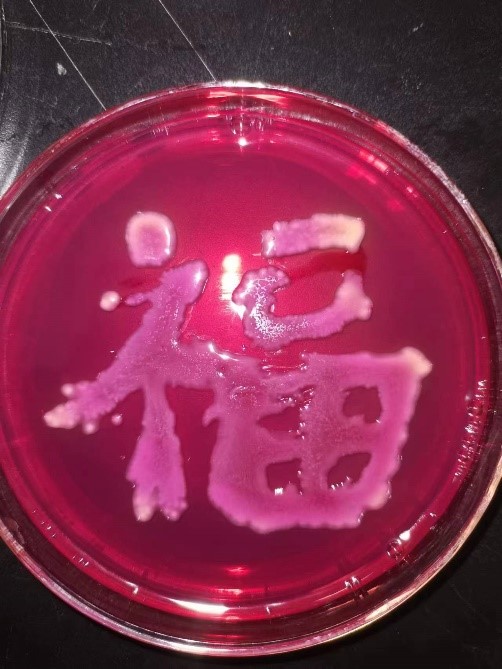

(学生通讯员 崔立雪 赖怡臣 汤家源)为响应中央号召,深入学习贯彻《中共中央国务院关于全面加强新时代大中小学劳动教育的意见》(下称《意见》)精神,加强大学生劳动教育、树立劳动观念,进一步提升学生实践能力,提高人才培养能力和教育教学水平,4月18日至4月30日,我院开展为期两周的劳动实践周系列活动,我院19级、20级、21级全体学生参加此次活动。
(一)实验室绿色化、安全化改造实践课堂
为加强学生对微免实验室操作安全教育和环保意识,帮助同学们深入感悟和践行绿色化学理念,4月25日,我院开展实验室绿色化、安全化改造实践课堂。期间,老师对实验室进行了专业化的介绍,系统讲解了微免实验室安全操作规程,并且指出了实验室绿色化、安全化改造的方向和仪器的正确使用和处理方法。同学们在老师的合理安排下分工明确,井然有序的进行了实验室整理劳动。学院运用和践行绿色理念,以劳增智促进学生全面发展,结合劳动教育来丰富实践周活动。不仅增强和提高了学生们的绿色和安全意识和劳动能力,还为我院人才培养起到重要的助推作用。

(二)药用植物识别校园实践活动
为使药学专业学生进一步了解药用植物和提高同学们的药用植物学实践能力,4月19日至4月22日,我院于校园内组织开展了药用植物识别校园实践活动,在实践过程中,李君玲老师详细讲解了植物的分类及其特征,对植物的药用价值也一一向同学们进行解答,同学们跟随老师们听讲植物的药用功能,学习有关药用植物的基础知识。同时为了培养学生的兴趣与动手能力,老师们还教导学生制作了一系列精美的标本。此次劳动实践活动的开展,不仅提升了大家的动手能力,还有利于同学们巩固药用植物学的基本理论和基本知识,同时也促进了药学专业同学们对于中药文化的了解,更为今后的专业课学习奠定坚实的基础。

(三)“我来为您做微课”知识科普大赛
为加强制药工程专业学生的综合能力,强化学生逻辑思维,4月25日至4月29日,我院在理工楼实验室举办“我来为您做微课”知识科普大赛。活动中,先由王春宝老师细致地讲解微课视频制作的基本技巧,学生们以微视频的形式展现制药工程相关的知识点,同时记录过程素材。具体开展过程分为四部分:确立讲解主题、细化讲解内容和讨论斟酌文案、视频元素拍摄与制作、视频后期处理。学生们动手实操,分工协作,互助完成了一次微课制作。最后,老师根据微课视频作品形式进行评分。本次比赛的成功举办,提升了同学们视频音频类软件实操能力和逻辑思维能力,对微课大赛有了更明确的认识和发展方向,更为我院人才培养起到了助推作用。

(四)中学教育名师专题讲座
为提升我院化学师范生的职业素养,强化学生的责任感和使命感。4月26日下午,我院举办了中学教育名师专题讲座。讲座中,老师根据自身的从教经验以“如何成为一名好老师”为主题,向同学们展开详细阐述。他提出,在新时代我们要做“四有”好老师,有理想信念、有道德情操、有扎实学识、有仁爱之心。他强调,要成为一名称职的教师,首先要成为一名优秀的见习者,“十年树木,百年树人”,从细微之处入手,富有责任心的态度,才能促使我们提高自身的素质,教育好每一位学生。此次讲座的举办,使得同学们深入了解到了作为一名好老师应当具备的素质和使命,也坚定了同学们对成为一名好老师的信心和决心。还有利于推动我院思想政治建设,培养德才兼备的社会主义青年。

(五)工程伦理知识讲座
为持续推进我院课程思政化有效建设,加强学生对工程伦理知识的深刻了解。秉承道德公平性和有效性原则,4月25日,我院开展工程伦理知识讲座。在本次讲座中,姜琼老师深刻论述了工程伦理的重要性,指出工程伦理是随着人类工程活动的发展而诞生的学问,面对这一结合现实实践和伦理考量的复杂命题,老师着眼于“创新”这一时代热点,通过教学视频分析创新的不同层次,逐渐引出新时代工程师应具备的素养与能力。此次讲座的顺利开展,进一步提高了同学们面对复杂因素作出正确判断和选择的能力,明确工程伦理规范和工程师伦理责任,同时也促进了我校“守正创新,坚持伦理”校园文化氛围的形成。

(六)实验室安全微视频大赛
为牢固树立实验室安全的红线意识和底线思维,进一步提高同学们的实验室安全防范意识和安全事故应急处理能力,我院举办了首届实验室安全微视频大赛。同学们基于实验室安全知识、实验操作规程等,发散思维,从不同角度创作出了多个作品,内容覆盖了气瓶安全、危化品安全、用水用电安全等多方面的实验室安全知识。参赛的同学们结合实验操作个人防护、危险化学品管理、用水用电安全、实验仪器使用规范等多方面实验室安全知识,从多个角度为大家制作出精彩的实验室安全微视频。此次大赛有效地营造了良好的实验室安全文化氛围,达到了实验室安全教育“我参与、我展示、我学习”的目的。


(七)电化学图案设计大赛
为加强大学生创新意识,增强自主实验能力,培养团队合作精神,利用电化学原理制作丰富的图案。我院于二教楼电化学实验室举行了电化学图案化设计大赛。此次比赛由朱凤老师设计课题,让学生自主设计电化学图案,用实践的方式了解电化学原理以及性质,我院19应化班全体同学参与了此次比赛。此次电化学图案化设计大赛,朱凤老师秉着“专业+艺术”的理念,帮助参赛同学学习了解电化学原理及性质,既提高了其自主实践设计能力,又促进了同学们对专业知识的巩固,且在学以致用能力的培养方面起了良好的助推作用。

(八)食品工程设计大赛
为巩固实践教学成果,4月29日上午,我院于二教楼食品实验室举行食品工程设计大赛。比赛的形式为分组逐一展示实践成果并讲解PPT,大赛由李秋红老师和叶文峰老师主持、点评和打分,19级食品专业全体学生参加了此次比赛。大赛的成功举办既有利于提升学生的设计与表达能力,又帮助他们为今后更好的使用相关的专业知识解决问题提供了新思路,面对更为我院培养高质量人才打下了坚实基础。

(九)药学产品推介大赛
为了加强药学专业学生的创新实践能力,4月29日,我院于人文楼教室开展了20级药学专业的药学产品设计及推介大赛。此次大赛的比赛形式为分组汇报,分别展示各组的药学产品设计成果并进行汇报讲解。汇报内容主要包括产品的设计理念、产品介绍、成分说明、功效、市场前景等,同时向大家展示各小组的制作和宣传视频。本次比赛的圆满举办,既使同学们对于药学产品设计有了初步的了解,又培养了大家的创新能力,增强了对药学的兴趣,更有利于营造我校优良的学习氛围。

(十)创意西点的制作
西点是西式餐饮烹饪的重要组成部分,它以用料讲究、造型艺术、品种丰富等特点,在西式餐饮中起着举足轻重的作用,是西方饮食文化的代表作品。裱花蛋糕是西点的主要产品之一。4月18-20日,我院于二教楼7楼食品工艺实验室面向食品专业学生开展了创意西点的制作。制作现场学生分成了7个小组,每个小组制作蛋糕坯一个。根据学院提供的原料及自己所带材料进行裱花,要求造型美观、构思巧妙、图案新颖、色泽淡雅和谐、主题突出、裱花精致。然后由老师综合评分,评选最好作品。本次劳动实践活动的开展,培养同学们热爱劳动的意识,懂得只有通过自己的双手创造出来的东西更有意义和价值,提高勇于探索和解决问题的实践能力,还能使同学们在团队合作中加强人际关系交流能力,提升团队合作精神,懂得劳动最光荣。

(十一)厨房里的艺术
为将教育教学活动充分贯穿于生活中,4月22日至25日,19化学班学生于理工楼实验室开展了厨房里的艺术劳动教育活动。本次活动在周健老师的指导下,从绿色环保的理念出发,将原本要丢弃的蔬果皮“变废为宝”,践行绿色生活、实现垃圾减量,同时借助简单的化学方法,提取紫薯皮中的花青素,再用厨房中的白醋和苏打,将其调制成多彩、鲜亮的植物颜料,画出令人赏心悦目的画作。在此次教育活动中,学生积极性非常高,参与度高,反应热烈。通过此次活动,培养学生分析问题并解决问题的能力,以此引导学生将书本知识转化为实际应用,激发他们深入学习化学理论知识的兴趣。此外,通过对生活中蔬果皮的处理和应用,培养学生认识美,发现美和创造美的能力,在丰富学生知识的同时达到以劳增智,以劳育美的目的。






(十二)细菌的艺术制作
4月19日-30日,20生物工程在理工楼实验室开展了细菌的艺术创作实践活动。本次活动由王瑞君、老师为指导老师,引导同学们以培养基为画布、以接种环为画笔、以菌株为颜料。根据不同微生物在同一种培养基或同一种微生物在不同培养基上呈现的颜色不同等微生物原理,在固体培养基上进行艺术创作。同学们设计不同的图案,创作出趣味生动、不同色彩的细菌艺术作品。通过本次实践活动,同学们创作的作品内容丰富,包括了有风景、动物、卡通、人物等方面。此次劳动实践活动,锻炼了同学们的微生物实验操作的专业技能、培养了学生的专业兴趣,也实现了专业素养与艺术修养完美结合。

劳动实践教育是国民教育体系的重要内容,是促进学生成长的重要方式,具有树德、增智、强体、育美的综合育人价值。我院高度重视劳动实践教育,在本次劳动实践周活动开展前精心部署,活动中精心组织安排,为了做好此项工作,我院四个领导分成四个小组认真开展检查工作,在检查中充分了解师生开展过程中存在的问题,并详细聆听师生的意见和建议,活动后及时进行总结,使得学院教育教学工作管理走向精细化、科学化,为学校的教学管理注入新的活力。
此次实践周的顺利开展,不仅展示了我院学生的劳动实践内容,还充分展现了学院师生的精神风采,并更加全面的诠释了我院学生的学习成果,为今后学院教学与学生管理工作起到了助推作用。
责编:汤家源
审核:陶华蕾